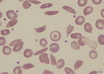

Trial establishes dosing and delivery protocols for direct oral anticoagulant in children
American Society of Hematology Annual Meeting Press Release | Dec 10, 2019
More bleeding events seen in patients taking aspirin plus a DOAC than a DOAC alone
American Society of Hematology Annual Meeting Press Release | Dec 10, 2019
Woman gets tongue made from arm skin
IANS | Dec 10, 2019
New building to come up at Rao Tula Ram Hospital, Delhi
PTI | Dec 10, 2019
Novel off-the-shelf CAR NK product overcomes CD19 antigen escape in preclinical studies
American Society of Hematology Annual Meeting Press Release | Dec 10, 2019
Dual-targeted antibody elicits durable responses in poor-prognosis non-hodgkin lymphoma (NHL)
American Society of Hematology Annual Meeting Press Release | Dec 10, 2019
ASH and FDA unveil new recommendations to guide clinical development of sickle cell disease therapies
American Society of Hematology Annual Meeting Press Release | Dec 10, 2019
Oral arginine supplements found helpful for children suffering SCD pain crises
American Society of Hematology Annual Meeting Press Release | Dec 10, 2019
Commercial antivenom used in India 'largely ineffective', finds IISc study
Partner Content | Dec 09, 2019
Most read this week